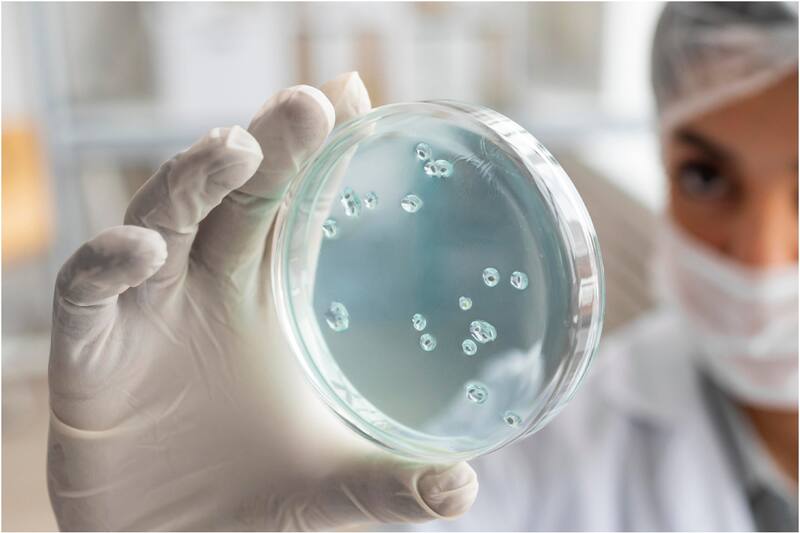

Por Paloma ParejaImpacto por desaparición de más de 300 frascos con virus mortales en Australia
Las autoridades descartan que hayan sido robados con motivos maliciosos como crear armas biológicas.
Tim Nicholls, ministro de Sanidad de Queensland, Australia, reveló esta semana que más de 300 frascos con virus mortales vivos desaparecieron del Public Health Virology Laboratory en 2021.
El profesional catalogó lo ocurrido como un “grave incumplimiento de los protocolos de bioseguridad”, informó Newsweek.
Nicholls confirmó al mencionado medio que fueron 323 los viales extraviados con virus vivos, dentro de ellos cerca de 100 frascos de Hendra, 223 de Lyssavirus y 2 de Hantavirus.
El accidente que ocurrió hace dos años fue descubierto recién este 2024, y confirmado oficialmente debido a la compleja autorización para abrir los congeladores donde se encontraban las muestras.
Una de las hipótesis que sostienen las autoridades es que los frascos hayan sido destruidos de acuerdo con el protocolo habitual del laboratorio.
Expertos llaman a mantener la calma
También se descarta que hayan sido robados con motivos maliciosos como de crear armas biológicas: “Es difícil concebir un escenario en el que el público pueda estar en riesgo. Es importante tener en cuenta que las muestras de virus se degradarían muy rápidamente fuera de un congelador de baja temperatura y dejarían de ser infecciosas” explicó John Gerrard, director de salud de Queensland.
Por este motivo, los expertos llaman a mantener la calma, ya que los virus solo podrían haber infectado a una persona si los frascos hubiesen sido abiertos después de sacarlos del frigorífico.
“Los virus dependen de la presencia de un huésped para sobrevivir. La mayoría de los virus tienen un tiempo de supervivencia muy limitado en el medio ambiente. Para mantener reservas infecciosas en los laboratorios, tienen que crecer en células o conservarse a temperaturas muy bajas”, explicó Andrew Preston, profesor de patogénesis microbial de la Universidad de Bath en Reino Unido.
Las autoridades iniciaron una investigación para determinar cómo se produjo la filtración, qué fallos de seguridad ocurrieron y qué medidas deben tomarse para evitarlo en un futuro.
Imperdibles
Lo último
22:00
22:06
21:40
19:59
18:50












